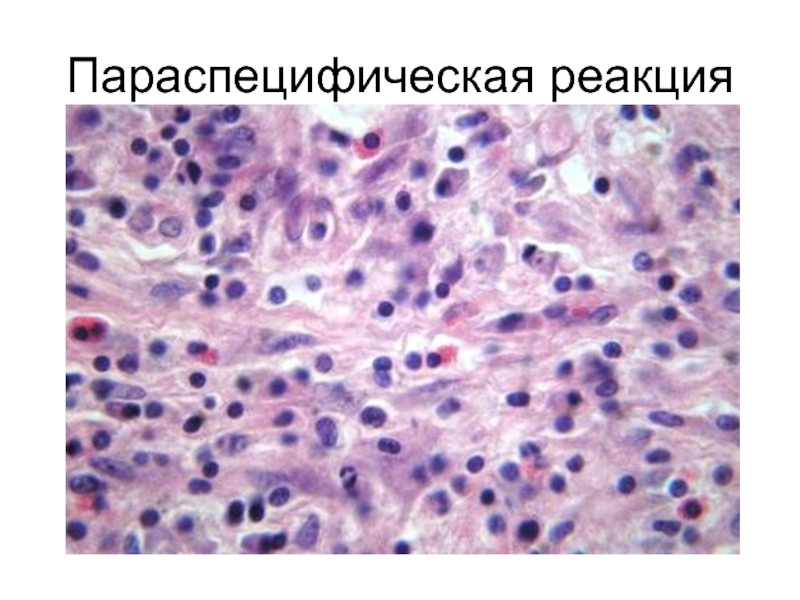

Разделы презентаций
- Разное
- Английский язык
- Астрономия
- Алгебра
- Биология
- География
- Геометрия
- Детские презентации
- Информатика
- История
- Литература
- Математика
- Медицина
- Менеджмент
- Музыка
- МХК
- Немецкий язык
- ОБЖ
- Обществознание
- Окружающий мир
- Педагогика
- Русский язык
- Технология
- Физика
- Философия
- Химия
- Шаблоны, картинки для презентаций
- Экология
- Экономика
- Юриспруденция
Рафаэль Три грации
Содержание
- 1. Рафаэль Три грации
- 2. Indocti discant et ament meminisse peritiНезнающие пусть научатся, а знающие пусть припоминают (не забывают)
- 3. Слайд 3
- 4. Слайд 4
- 5. Слайд 5
- 6. Слайд 6
- 7. Слайд 7
- 8. Слайд 8
- 9. Слайд 9
- 10. Параспецифическая реакция
- 11. Параспецифическая реакция
- 12. Параспецифическая реакция
- 13. Лимфоидная инфильтрация плевры
- 14. Инфильтрация межальвеолярных перегородок
- 15. Панваскулит
- 16. Фибриноидный некроз межальвеолярных перегородок
- 17. Мелкоочаговый пневмосклероз
- 18. Слайд 18
- 19. Туберкулезный менингит
- 20. Слайд 20
- 21. Слайд 21
- 22. Слайд 22
- 23. Слайд 23
- 24. Слайд 24
- 25. Слайд 25
- 26. Слайд 26
- 27. Слайд 27
- 28. Слайд 28
- 29. Слайд 29
- 30. Слайд 30
- 31. Слайд 31
- 32. Слайд 32
- 33. Слайд 33
- 34. Слайд 34
- 35. Слайд 35
- 36. «Очень часто смерть инфекционных больных объясняют и
- 37. Слайд 37
- 38. Слайд 38
- 39. Слайд 39
- 40. А.Дюрер Четыре ведьмы
- 41. Слайд 41
- 42. Пусть ВАС вдохновляют слова академика П.Л.Капицы, сказанные
- 43. Скачать презентанцию
Indocti discant et ament meminisse peritiНезнающие пусть научатся, а знающие пусть припоминают (не забывают)
Слайды и текст этой презентации
Слайд 36«Очень часто смерть инфекционных больных объясняют и н т о
к с и к а ц и е й, имея
в виду микробов-возбудителей, продукты их жизнедеятельности, а также продукты обмена. Отрицать воздействие этих факторов на организм и нервную систему не приходится. Однако и сводить к интоксикации все общие явления, наблюдаемые при инфекциях, а также причины смерти неправильно хотя бы потому, что этот термин не раскрывает сам механизм интоксикации, не говоря уже о том, что последняя обычно остается недоказанной. Возьмем, к примеру, столь часто употребляемые термины «токсическая дизентерия», «токсический грипп» и «гипертоксическая дифтерия» и т.д. Здесь происходит смешение субъективного с объективным, ибо вместо того, чтобы тяжесть общих явлений пытаться раскрыть физиологическими методами, мы чисто субъективно, по принципу внешнего сходства этих общих явлений с интоксикацией принимаем их за таковую. В огромном количестве соответствующих случаев никакой интоксикации вообще нет, т. е. нет никакого яда, отравляющего организм, а имеют место тяжелые расстройства нервной деятельности организма с глубокими обменными сдвигами, ставящими организм на грань жизни.»И.В. Давыдовский